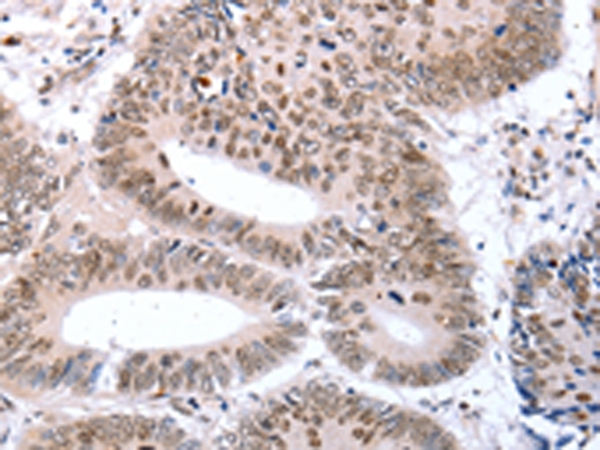

-
分类: 科研抗体货号: P03957别名: BB2应用: WB,IHC反应种属: Human, Mouse, Rat
-
分类: 科研抗体货号: P03887别名: ED1, HED, EDA1, EDA2, ODT1, XHED, XLHED, ED1-A1, ED1-A2, STHAGX1应用: WB,IHC反应种属: Human, Mouse
-
分类: 科研抗体货号: P04007别名: HE6; EDDM6; GPR64; CBAVDX; TM7LN2应用: IHC反应种属: Human
-
分类: 科研抗体货号: P03955别名: GAL7; LGALS7A应用: IHC反应种属: Human
-
分类: 科研抗体货号: P03886别名: C2orf40应用: IHC反应种属: Human, Mouse, Rat
-
分类: 科研抗体货号: P04005别名: UTR, UTR2, GPR14, UR-2-R应用: WB反应种属: Human
-
分类: 科研抗体货号: P03943别名:应用: IHC反应种属: Human, Mouse
-
分类: 科研抗体货号: P03883别名: EAAT2, GLT-1应用: IHC反应种属: Human, Mouse, Rat
-
分类: 科研抗体货号: P03998别名: GLUT8; GLUT12应用: WB反应种属: Human
-
分类: 科研抗体货号: P03942别名: SPCH1; CAGH44; TNRC10应用: IHC反应种属: Human, Mouse, Rat

鄂公网安备42018502007531号
鄂公网安备42018502007531号

